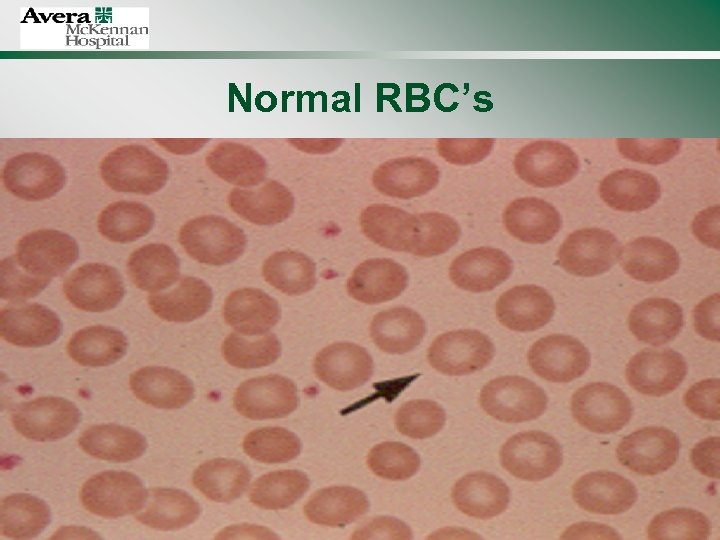
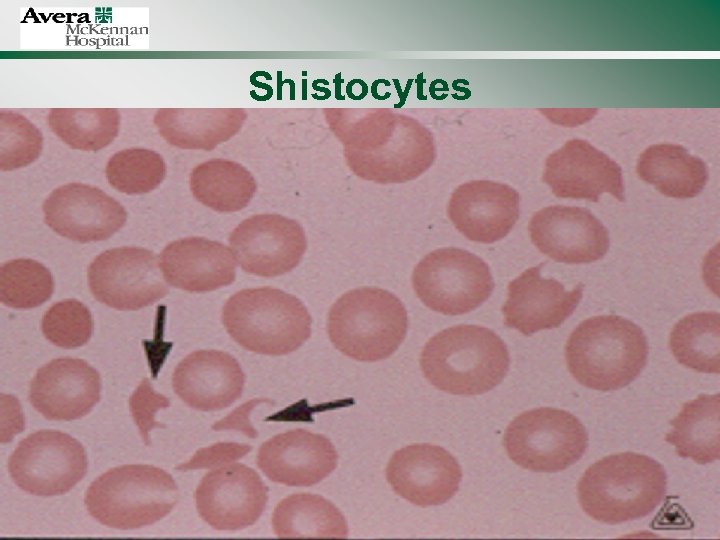

a1d14a084955d32721fa768807d75efe.ppt
- Количество слайдов: 71
 Hypertensive Disorders in Pregnancy
Hypertensive Disorders in Pregnancy
 Hypertensive Disorders of Pregnancy • Occur in 6 -8% of all pregnancies • 2 nd leading cause of maternal death in the U. S. – Due to lethal complications of abruption, DIC, cerebral hemorrhage, hepatic failure, and acute renal failure • Different from non-pregnant care, in that 2 patients (or more) to consider, severe complications can occur rapidly within hrs of initial diagnosis • HTN &/or proteinuria in pregnancy are leading risk factors associated with stillbirth, resulting in 1 in 5 stillbirths in otherwise viable babies • Serious sequelae of preeclampsia can persist for up to 5 days postpartum
Hypertensive Disorders of Pregnancy • Occur in 6 -8% of all pregnancies • 2 nd leading cause of maternal death in the U. S. – Due to lethal complications of abruption, DIC, cerebral hemorrhage, hepatic failure, and acute renal failure • Different from non-pregnant care, in that 2 patients (or more) to consider, severe complications can occur rapidly within hrs of initial diagnosis • HTN &/or proteinuria in pregnancy are leading risk factors associated with stillbirth, resulting in 1 in 5 stillbirths in otherwise viable babies • Serious sequelae of preeclampsia can persist for up to 5 days postpartum
 NHBPEP * • Advocates discarding the term PIH because it does not differentiate between gestational hypertension (relatively benign disorder) and the more serious preeclampsia • HTN SBP > 140 mm. Hg; DBP > 90 mm. Hg * U. S. National High Blood Pressure Education Program
NHBPEP * • Advocates discarding the term PIH because it does not differentiate between gestational hypertension (relatively benign disorder) and the more serious preeclampsia • HTN SBP > 140 mm. Hg; DBP > 90 mm. Hg * U. S. National High Blood Pressure Education Program
 NHBPEP (2000) • Chronic hypertension • Preeclampsia-eclampsia • Preeclampsia superimposed on chronic hypertension • Gestational hypertension
NHBPEP (2000) • Chronic hypertension • Preeclampsia-eclampsia • Preeclampsia superimposed on chronic hypertension • Gestational hypertension
 Chronic Hypertension (NHBPEP) • Chronic Hypertension – HTN prior to conception, or diagnosed before 20 th week of gestation that does not resolve postpartum
Chronic Hypertension (NHBPEP) • Chronic Hypertension – HTN prior to conception, or diagnosed before 20 th week of gestation that does not resolve postpartum
 Preeclampsia-Eclampsia (NHBPEP) • Preeclampsia – Systemic disease with hypertension accompanied by proteinuria after 20 th week gestation – May be dx without proteinuria if other systemic symptoms such as visual changes, HA, abdominal pain, or abnormal lab values • Eclampsia – Convulsive stage, when seizures cannot be attributed to other causes
Preeclampsia-Eclampsia (NHBPEP) • Preeclampsia – Systemic disease with hypertension accompanied by proteinuria after 20 th week gestation – May be dx without proteinuria if other systemic symptoms such as visual changes, HA, abdominal pain, or abnormal lab values • Eclampsia – Convulsive stage, when seizures cannot be attributed to other causes
 Preeclampsia Superimposed on Chronic HTN (NHBPEP) • Hypertensive women who develop new onset proteinuria; proteinuria before 20 th week gestation; or sudden uncontrolled HTN • Women with both HTN & proteinuria < 20 wks gestation • Women with previously controlled HTN who have sudden ↑ in BP • Women with thrombocytopenia (< 100, 000 cells/mm 3 and elevated hepatic enzymes (AST or ALT)
Preeclampsia Superimposed on Chronic HTN (NHBPEP) • Hypertensive women who develop new onset proteinuria; proteinuria before 20 th week gestation; or sudden uncontrolled HTN • Women with both HTN & proteinuria < 20 wks gestation • Women with previously controlled HTN who have sudden ↑ in BP • Women with thrombocytopenia (< 100, 000 cells/mm 3 and elevated hepatic enzymes (AST or ALT)
 Gestational HTN (NHBPEP) • The term “Gestational HTN” may be used in pregnancy until a more specific dx can be made, which is often not until postpartum. • High BP detected for the first time after midpregnancy, without proteinuria • May be transient or chronic in nature • Dx used only during pregnancy with definitive diagnosis made postpartum • Relatively benign disorder with good outcomes (which is why NHBPEP eliminated the term PIH) – important differences in the pathogenesis of the disorders
Gestational HTN (NHBPEP) • The term “Gestational HTN” may be used in pregnancy until a more specific dx can be made, which is often not until postpartum. • High BP detected for the first time after midpregnancy, without proteinuria • May be transient or chronic in nature • Dx used only during pregnancy with definitive diagnosis made postpartum • Relatively benign disorder with good outcomes (which is why NHBPEP eliminated the term PIH) – important differences in the pathogenesis of the disorders
 Gestational HTN • Elevated BP during pregnancy with no preeclampsia and BP returns to normal within 12 weeks postpartum
Gestational HTN • Elevated BP during pregnancy with no preeclampsia and BP returns to normal within 12 weeks postpartum
 Normal Pregnancy Changes • Markedly vasodilated state – Peripheral resistance ↓ 25% due to ↑ in prostacyclin (potent vasodilator) and endothelium-derived relaxing factor • 50% ↑ in total blood volume by end 2 nd trimester • CO ↑ in 1 st trimester, peaking at 35% to 50% above non-pregnant levels
Normal Pregnancy Changes • Markedly vasodilated state – Peripheral resistance ↓ 25% due to ↑ in prostacyclin (potent vasodilator) and endothelium-derived relaxing factor • 50% ↑ in total blood volume by end 2 nd trimester • CO ↑ in 1 st trimester, peaking at 35% to 50% above non-pregnant levels
 Normal Pregnancy Changes • ↑ renal blood flow, ↑ GFR, activation of renin-aldosterone system (results in falling BP) • DBP drops to an average of 10 mm. Hg below non-pregnant values by midpregnancy, then slowly approaches non-gravid levels in 3 rd trimester
Normal Pregnancy Changes • ↑ renal blood flow, ↑ GFR, activation of renin-aldosterone system (results in falling BP) • DBP drops to an average of 10 mm. Hg below non-pregnant values by midpregnancy, then slowly approaches non-gravid levels in 3 rd trimester
 Pathophysiology of Pre-Eclampsia • “Disease of theories” - no established cause • 2 stages: – Disruptions in placental perfusion – Maternal syndrome • Abnormal prostacyclin: thromboxane ratios • Prostacyclin vasodilation and inhibits platelet aggregation • Thromboxane vasoconstriction and platelet aggregation
Pathophysiology of Pre-Eclampsia • “Disease of theories” - no established cause • 2 stages: – Disruptions in placental perfusion – Maternal syndrome • Abnormal prostacyclin: thromboxane ratios • Prostacyclin vasodilation and inhibits platelet aggregation • Thromboxane vasoconstriction and platelet aggregation
 Disruptions in Placental Perfusion • Normal pregnancy: cells from placenta invade the maternal spiral arteries, causing the vessels to change from thick-walled vessels to flaccid sac-like vessels • Results in ↑ vessel diameter and expansion to accommodate the 10 -fold ↑ in uterine blood flow
Disruptions in Placental Perfusion • Normal pregnancy: cells from placenta invade the maternal spiral arteries, causing the vessels to change from thick-walled vessels to flaccid sac-like vessels • Results in ↑ vessel diameter and expansion to accommodate the 10 -fold ↑ in uterine blood flow
 • In preeclampsia, the vessels remain thick-walled and a distinctive lesion (acute atherosis) noted • These lesions, along with placental infarcts, lead to ↓ placental perfusion and hypoxia • It is the placental hypoxia that is believed to be the initial cause of preeclampsia
• In preeclampsia, the vessels remain thick-walled and a distinctive lesion (acute atherosis) noted • These lesions, along with placental infarcts, lead to ↓ placental perfusion and hypoxia • It is the placental hypoxia that is believed to be the initial cause of preeclampsia
 Maternal Syndrome • Normal pregnancy: – Systemic vasorelaxation occurs, results in ↑ blood volume, HR, CO • Preeclampsia – Blood vessels become hypersensitive to vasoactive hormones and vasoconstriction occurs
Maternal Syndrome • Normal pregnancy: – Systemic vasorelaxation occurs, results in ↑ blood volume, HR, CO • Preeclampsia – Blood vessels become hypersensitive to vasoactive hormones and vasoconstriction occurs
 Widespread Vasospasm • Arterial vasospasm • Disrupts arterial & venous circulation due to alternating segments of constriction & dilatation, resulting in endothelial damage • Vascular wall damage activates platelet aggregation, intravascular volume, results in tissue ischemia from impaired blood flow to organs • BP rises as result of narrowed lumens (vasoconstriction) and high resistance state
Widespread Vasospasm • Arterial vasospasm • Disrupts arterial & venous circulation due to alternating segments of constriction & dilatation, resulting in endothelial damage • Vascular wall damage activates platelet aggregation, intravascular volume, results in tissue ischemia from impaired blood flow to organs • BP rises as result of narrowed lumens (vasoconstriction) and high resistance state
 Risk Factors for PIH • Primip or 1 st preg. w/new partner • Women < 17 or > 35 years of age • Women w/diabetes, pre-existing vascular diseases, HTN, or renal disease • Multi-fetal pregnancies • PIH hx (self/family) • Obesity • Vascular & connective tissue disease • Antiphospholipid antibody syndrome • Lack of drop in 2 nd trimester BP (16 -18 wks)
Risk Factors for PIH • Primip or 1 st preg. w/new partner • Women < 17 or > 35 years of age • Women w/diabetes, pre-existing vascular diseases, HTN, or renal disease • Multi-fetal pregnancies • PIH hx (self/family) • Obesity • Vascular & connective tissue disease • Antiphospholipid antibody syndrome • Lack of drop in 2 nd trimester BP (16 -18 wks)
 Urine Test to Detect Pre-Eclampsia • Development of a urine test to check for levels of placental growth factor (a protein that nurtures blood vessels that support the mother and fetus) • Journal of American Medical Assn. (Jan. 05) – Compared samples from women who developed PIH with those who didn’t – Those w/the lowest placental growth factor levels were ~ 23 x more likely to develop preeclampsia b/4 37 wks than others – Anticipate 4 years until available
Urine Test to Detect Pre-Eclampsia • Development of a urine test to check for levels of placental growth factor (a protein that nurtures blood vessels that support the mother and fetus) • Journal of American Medical Assn. (Jan. 05) – Compared samples from women who developed PIH with those who didn’t – Those w/the lowest placental growth factor levels were ~ 23 x more likely to develop preeclampsia b/4 37 wks than others – Anticipate 4 years until available
 Effects on Systems/Organs • • • C = Cardiovascular H = Hematologic H = Hepatic U = Uteroplacental R = Renal N = Neurologic
Effects on Systems/Organs • • • C = Cardiovascular H = Hematologic H = Hepatic U = Uteroplacental R = Renal N = Neurologic
 Cardiovascular • Hypertension – arterial vasospasm SVR, HTN, edema – organ perfusion • Assessments – BP x 2 at least 6 hrs apart – BP assessments - appropriate cuff size, lateral recumbent, use dependent arm, arm at heart level, record Korotkoff IV (muffling) & V (disappearance) – focus on trends – may also see tachycardia
Cardiovascular • Hypertension – arterial vasospasm SVR, HTN, edema – organ perfusion • Assessments – BP x 2 at least 6 hrs apart – BP assessments - appropriate cuff size, lateral recumbent, use dependent arm, arm at heart level, record Korotkoff IV (muffling) & V (disappearance) – focus on trends – may also see tachycardia
 Manual vs Electronic BP • Electronic BP devices produce different values that a manual cuff/stethoscope – Electronic devices systematically under estimate DBP by approx. 10 mm. Hg and overestimate SBP values by approx. 4 -6 mm. Hg. – Related to the normal hemodynamic changes that occur w/pregnancy & changes in Korotkoff phases heard with the ear vs the electronic device.
Manual vs Electronic BP • Electronic BP devices produce different values that a manual cuff/stethoscope – Electronic devices systematically under estimate DBP by approx. 10 mm. Hg and overestimate SBP values by approx. 4 -6 mm. Hg. – Related to the normal hemodynamic changes that occur w/pregnancy & changes in Korotkoff phases heard with the ear vs the electronic device.
 AHA Recommendations • Oscillometric BP monitor be validated on each patient before readings are accepted • Compare automated reading with mercury BP cuff reading • Also, since BP can vary > 10 mm. Hg depending on which arm is used, BP should be checked in both arms at the initial exam – If consistent inter-arm differences found, should use the arm with the higher reading
AHA Recommendations • Oscillometric BP monitor be validated on each patient before readings are accepted • Compare automated reading with mercury BP cuff reading • Also, since BP can vary > 10 mm. Hg depending on which arm is used, BP should be checked in both arms at the initial exam – If consistent inter-arm differences found, should use the arm with the higher reading
 R/O White Coat HTN • ~ 15 to 30% of the general population exhibits “white coat” HTN, but a higher incidence is noted among the elderly and among pregnant women
R/O White Coat HTN • ~ 15 to 30% of the general population exhibits “white coat” HTN, but a higher incidence is noted among the elderly and among pregnant women
 Hematologic • Vasospasm vascular damage • hct – inadequate plasma volume expansion – blood viscosity, maternal organ perfusion • Thrombocytopenia – schistocytes, burr cells – bili – hemolysis compromises tissue O 2 delivery
Hematologic • Vasospasm vascular damage • hct – inadequate plasma volume expansion – blood viscosity, maternal organ perfusion • Thrombocytopenia – schistocytes, burr cells – bili – hemolysis compromises tissue O 2 delivery
Normal RBC’s
Normal RBC’s
Shistocytes
Shistocytes
 Burr Cells
Burr Cells
 Hematologic • Change in plasma proteins – Colloid oncotic pressure -- “pulling pressure of proteins” • Hydrostatic (water) pressure – pushing pressure of intravascular fluid against the vessel walls – balance of these 2 maintains fluid levels in capillaries – If COP < hydrostatic pressure, fluid moves rapidly out of capillaries
Hematologic • Change in plasma proteins – Colloid oncotic pressure -- “pulling pressure of proteins” • Hydrostatic (water) pressure – pushing pressure of intravascular fluid against the vessel walls – balance of these 2 maintains fluid levels in capillaries – If COP < hydrostatic pressure, fluid moves rapidly out of capillaries
 Hematologic • Hemoconcentration – due to capillary permeability, plasma volume – tissue perfusion, reduced blood flow – norm is hemodilution & physiologic anemia • DIC – rare, may occur if severe PIH • HELLP – clotting studies, liver function tests
Hematologic • Hemoconcentration – due to capillary permeability, plasma volume – tissue perfusion, reduced blood flow – norm is hemodilution & physiologic anemia • DIC – rare, may occur if severe PIH • HELLP – clotting studies, liver function tests
 HELLP Syndrome • A variant of severe pre-eclampsia • H = Hemolysis • EL = Elevated Liver enzymes – 2 x normal • LP = Low Platelets – < 100, 000
HELLP Syndrome • A variant of severe pre-eclampsia • H = Hemolysis • EL = Elevated Liver enzymes – 2 x normal • LP = Low Platelets – < 100, 000
 Assessment • Look for s/s bleeding • Monitor labs - watch for platelet count, lab value changes • Observe for s/s of anemia • Observe for adequate oxygenation
Assessment • Look for s/s bleeding • Monitor labs - watch for platelet count, lab value changes • Observe for s/s of anemia • Observe for adequate oxygenation
 Hepatic • Vasospasm & fibrin deposits may obstruct blood flow & cause ischemic changes in liver • Ischemia, necrosis, and intrahepatic hemorrhage can lead to hepatic rupture • liver enzymes due to poorly perfused liver • Glucose metabolism, excretion of drugs may be affected
Hepatic • Vasospasm & fibrin deposits may obstruct blood flow & cause ischemic changes in liver • Ischemia, necrosis, and intrahepatic hemorrhage can lead to hepatic rupture • liver enzymes due to poorly perfused liver • Glucose metabolism, excretion of drugs may be affected
 Assessments • Assess for RUQ epigastric pain, substernal pain, tenderness to palpation • N/V, malaise, viral-like syndrome • Monitor labs for liver function – AST, ALT, LDH, bilirubin
Assessments • Assess for RUQ epigastric pain, substernal pain, tenderness to palpation • N/V, malaise, viral-like syndrome • Monitor labs for liver function – AST, ALT, LDH, bilirubin
 Uteroplacental System • Physiology: • Vasospasm causes in uteroplacental perfusion • in O 2 and nutrients to fetus • risk placental abruption • Assessment: • Evaluate FHR pattern, watch for signs of perfusion & O 2 • Assess UC activity/pattern • Fetal surveillance for activity, growth, AFV
Uteroplacental System • Physiology: • Vasospasm causes in uteroplacental perfusion • in O 2 and nutrients to fetus • risk placental abruption • Assessment: • Evaluate FHR pattern, watch for signs of perfusion & O 2 • Assess UC activity/pattern • Fetal surveillance for activity, growth, AFV
 Renal System • Vasospasm & damage results in flow through kidneys, GFR, creatinine clearance, and urinary output – normal pregnancy, renal plasma volume & GFR 30 -50% • Kidneys unable to excrete waste products (urea, creatinine, uric acid) • Proteinuria due to kidney damage, larger molecules leak out • Important to remember when giving meds excreted by kidneys, ie, Mg. SO 4
Renal System • Vasospasm & damage results in flow through kidneys, GFR, creatinine clearance, and urinary output – normal pregnancy, renal plasma volume & GFR 30 -50% • Kidneys unable to excrete waste products (urea, creatinine, uric acid) • Proteinuria due to kidney damage, larger molecules leak out • Important to remember when giving meds excreted by kidneys, ie, Mg. SO 4
 Renal (con’t) • Proteinuria - classic sign • Decreased urine output • Edema
Renal (con’t) • Proteinuria - classic sign • Decreased urine output • Edema
 Renal Assessment/Care • • Weight gain Edema Breath sounds Pulse ox Strict I&O Infusion pumps Hourly output, call if < 30 cc/hr • Watch Mg levels closely • Monitor urine protein • Monitor lab values: – – H&H BUN creatinine uric acid
Renal Assessment/Care • • Weight gain Edema Breath sounds Pulse ox Strict I&O Infusion pumps Hourly output, call if < 30 cc/hr • Watch Mg levels closely • Monitor urine protein • Monitor lab values: – – H&H BUN creatinine uric acid
 Neurologic System • ↓ cerebral perfusion due to HTN • Vessel damage & vasospasm can cause intracranial pressure, cerebral edema, ischemia, hemorrhage • S/S: drowsiness, tinnitus, visual disturbances (blurred vision, photophobia), persistent HAs, N/V • Hyperreflexia & clonus • Seizure
Neurologic System • ↓ cerebral perfusion due to HTN • Vessel damage & vasospasm can cause intracranial pressure, cerebral edema, ischemia, hemorrhage • S/S: drowsiness, tinnitus, visual disturbances (blurred vision, photophobia), persistent HAs, N/V • Hyperreflexia & clonus • Seizure
 Neurologic Assessment • Assess for HA, visual disturbances, drowsiness, N/V, altered LOC, hypersensitive to noise/light • Assess DTR’s/clonus • Monitor Mg level • Assess for s/s of seizure, protective environment, seizure tray at bedside
Neurologic Assessment • Assess for HA, visual disturbances, drowsiness, N/V, altered LOC, hypersensitive to noise/light • Assess DTR’s/clonus • Monitor Mg level • Assess for s/s of seizure, protective environment, seizure tray at bedside
 DTR’s • • • 0 No response, hypoactive, abnormal +1 Somewhat diminished, not abnormal 2+ Average response 3+ Brisker than average, not abnormal 4+ Hyperactive, very brisk, abnormal
DTR’s • • • 0 No response, hypoactive, abnormal +1 Somewhat diminished, not abnormal 2+ Average response 3+ Brisker than average, not abnormal 4+ Hyperactive, very brisk, abnormal
 Clonus • Repetitive, rhythmic contractions of a muscle when attempting to hold it in a stretched state • A strong, deep tendon reflex that occurs when the CNS fails to inhibit it • Often tested for in the ankle, wrist, and kneecap • Normal = no beats • Video http: //www. mult-sclerosis. org/clonus. html
Clonus • Repetitive, rhythmic contractions of a muscle when attempting to hold it in a stretched state • A strong, deep tendon reflex that occurs when the CNS fails to inhibit it • Often tested for in the ankle, wrist, and kneecap • Normal = no beats • Video http: //www. mult-sclerosis. org/clonus. html
 Neurologic Assessments • • Pupil size (equal, size, reactive) Hand grasp Level of consciousness Response to painful stimuli
Neurologic Assessments • • Pupil size (equal, size, reactive) Hand grasp Level of consciousness Response to painful stimuli
 Other Nsg Assessments • Emotional health assessment – communicate w/patient/family – referrals as necessary • Provide education – disease process – procedures, pertinent policies – explain equipment to family
Other Nsg Assessments • Emotional health assessment – communicate w/patient/family – referrals as necessary • Provide education – disease process – procedures, pertinent policies – explain equipment to family
 Treatment Options • Mild preeclampsia • Severe preeclampsia
Treatment Options • Mild preeclampsia • Severe preeclampsia
 Mild Preeclampsia • May be managed at home if: – EGA > 20 weeks – BP <150/100 sitting or <140/90 lateral – Proteinuria < 100 mg/L dipstick or < 1 gm/24 – No evidence of HA w/visual disturbances, epigastric pain, edema, clonus – Labs: platelets >100, 000, AST < 50 U/L, ALT < 200 U/L, serum creatine < 1. 32 mg/dl or within normal limits – Able to use home BP equipment
Mild Preeclampsia • May be managed at home if: – EGA > 20 weeks – BP <150/100 sitting or <140/90 lateral – Proteinuria < 100 mg/L dipstick or < 1 gm/24 – No evidence of HA w/visual disturbances, epigastric pain, edema, clonus – Labs: platelets >100, 000, AST < 50 U/L, ALT < 200 U/L, serum creatine < 1. 32 mg/dl or within normal limits – Able to use home BP equipment
 Home Assessments • Effects of bedrest • Common physical complaints • Emotional effects • Social/financial implications
Home Assessments • Effects of bedrest • Common physical complaints • Emotional effects • Social/financial implications
 Self-Care at Home • BP 2 -4 x daily, same arm/same position • Daily weight (same time, same scale) • Urine dipstick 1 st AM void (may collect 24 hr urine weekly) • Daily fetal kick counts • Weekly RN visits • Daily phone calls • Hospitalize if S/S worsen
Self-Care at Home • BP 2 -4 x daily, same arm/same position • Daily weight (same time, same scale) • Urine dipstick 1 st AM void (may collect 24 hr urine weekly) • Daily fetal kick counts • Weekly RN visits • Daily phone calls • Hospitalize if S/S worsen
 Severe Preeclampsia Management • Inpatient management – Bedrest – Frequent BP assessment – Assess for s/s disease worsening – Medications to prevent seizures & control BP
Severe Preeclampsia Management • Inpatient management – Bedrest – Frequent BP assessment – Assess for s/s disease worsening – Medications to prevent seizures & control BP
 Medication Considerations • • • Diastolic BP > 105 -110 mm. Hg Systolic BP > 200 Avoid rapid reduction in BP Don’t attempt to “normalize” BP Goal is DBP < 105 not < 90 – may precipitate fetal distress
Medication Considerations • • • Diastolic BP > 105 -110 mm. Hg Systolic BP > 200 Avoid rapid reduction in BP Don’t attempt to “normalize” BP Goal is DBP < 105 not < 90 – may precipitate fetal distress

 Characteristics of Severe HTN • Crises are associated with hypovolemia • Clinical assessment of hydration is inaccurate • Unprotected vascular beds are at risk, i. e. , uterine
Characteristics of Severe HTN • Crises are associated with hypovolemia • Clinical assessment of hydration is inaccurate • Unprotected vascular beds are at risk, i. e. , uterine
 Common Medications - See Med Sheet • • Magnesium sulfate Hydralazine Nifedipine Labetalol
Common Medications - See Med Sheet • • Magnesium sulfate Hydralazine Nifedipine Labetalol
 Mg. SO 4 • • Drug of choice - CNS depressant Loading dose maintenance dose Therapeutic range 5 -8 mg/dl Antidote - calcium gluconate Maternal side effects Fetal effects Nursing implications
Mg. SO 4 • • Drug of choice - CNS depressant Loading dose maintenance dose Therapeutic range 5 -8 mg/dl Antidote - calcium gluconate Maternal side effects Fetal effects Nursing implications
 Mg Levels & Toxicity Sign or Symptom Loss of patellar reflexes Feeling of warmth/flushing Somnolence Slurred speech Muscular paralysis Respiratory depression Cardiotoxicity Mg Level (mg/dl) 8 -12 9 -12 10 -12 15 -17 30 -35
Mg Levels & Toxicity Sign or Symptom Loss of patellar reflexes Feeling of warmth/flushing Somnolence Slurred speech Muscular paralysis Respiratory depression Cardiotoxicity Mg Level (mg/dl) 8 -12 9 -12 10 -12 15 -17 30 -35
 Vasodilators • Pre-hydrate with 250 -500 cc crystalloid IV fluid • Avoid multiple doses in rapid succession • Allow time for drug to work • Maintain R or L recumbent position • Avoid over-treatment
Vasodilators • Pre-hydrate with 250 -500 cc crystalloid IV fluid • Avoid multiple doses in rapid succession • Allow time for drug to work • Maintain R or L recumbent position • Avoid over-treatment
 Apresoline • • • Antihypertensive, vasodilator Dosing Maternal side effects Fetal effects Nursing implications
Apresoline • • • Antihypertensive, vasodilator Dosing Maternal side effects Fetal effects Nursing implications
 Nifedipine • Calcium channel blocker - intravascular resistance and C. O. • Dosing • Maternal side effects • Fetal effects • Nursing implications
Nifedipine • Calcium channel blocker - intravascular resistance and C. O. • Dosing • Maternal side effects • Fetal effects • Nursing implications
 Labetalol • Beta blocker - reduce arterial vasospasm, BP, prevent vascular injury • Dosing • Maternal side effects • Fetal effects • Nursing implications
Labetalol • Beta blocker - reduce arterial vasospasm, BP, prevent vascular injury • Dosing • Maternal side effects • Fetal effects • Nursing implications
 Treatment of Eclampsia • Goal is to protect the patient • Avoid insertion of airways and padded tongue blades - can cause upper airway trauma and hemorrhage • IV access • Suction, O 2 • Mg. SO 4 4 -6 g bolus, if not effective, give another 2 g
Treatment of Eclampsia • Goal is to protect the patient • Avoid insertion of airways and padded tongue blades - can cause upper airway trauma and hemorrhage • IV access • Suction, O 2 • Mg. SO 4 4 -6 g bolus, if not effective, give another 2 g
 Alternative Anticonvulsants • Diazepam 5 -10 mg IV (long half-life in fetus) • Sodium Amytal 100 mg IV • Pentobarbital 125 mg IV • Dilantin 500 -1000 mg IV infusion
Alternative Anticonvulsants • Diazepam 5 -10 mg IV (long half-life in fetus) • Sodium Amytal 100 mg IV • Pentobarbital 125 mg IV • Dilantin 500 -1000 mg IV infusion
 Post Seizure Care • Assess maternal labs • Assess fetal well-being, inutero resuscitation • Plan for delivery, induction okay if cervical readiness • No need for immediate C/S
Post Seizure Care • Assess maternal labs • Assess fetal well-being, inutero resuscitation • Plan for delivery, induction okay if cervical readiness • No need for immediate C/S
 Other Complications • Pulmonary edema – Fluid overload & COP – Occurs more often after delivery – Lasix 10 -20 mg IV • Oliguria – Goal at least 30 cc/hr – Small fluid boluses (250 -500 cc) – PP diuresis common
Other Complications • Pulmonary edema – Fluid overload & COP – Occurs more often after delivery – Lasix 10 -20 mg IV • Oliguria – Goal at least 30 cc/hr – Small fluid boluses (250 -500 cc) – PP diuresis common
 Other Complications • Persistent hypertension – BP may remain for several days – DBP < 100 don’t require treatment – by definition, preeclampsia resolves by 6 weeks • DIC – rarely occurs without abruption – low platelets is not DIC – requires blood products & delivery
Other Complications • Persistent hypertension – BP may remain for several days – DBP < 100 don’t require treatment – by definition, preeclampsia resolves by 6 weeks • DIC – rarely occurs without abruption – low platelets is not DIC – requires blood products & delivery
 Postpartum Course • Cardiogenic – Rapid improvement ? Hemorrhage – Blood loss not tolerated well – Use of methergine contraindicated – Watch for uterine hypotonus w/Mg. SO 4 – in BP and U. O. may indicate hemorrhage and shock
Postpartum Course • Cardiogenic – Rapid improvement ? Hemorrhage – Blood loss not tolerated well – Use of methergine contraindicated – Watch for uterine hypotonus w/Mg. SO 4 – in BP and U. O. may indicate hemorrhage and shock
 Postpartum • Hematologic – Thrombocytopenia resolves ~ 3 days • Hepatic – Improvement in liver function studies • Uteroplacental – Monitor vag flow closely, weigh pads – Watch uterine tone
Postpartum • Hematologic – Thrombocytopenia resolves ~ 3 days • Hepatic – Improvement in liver function studies • Uteroplacental – Monitor vag flow closely, weigh pads – Watch uterine tone
 Postpartum • Renal – Improvement in urine output – Large diuresis sign of recovery – Improvement in BUN, creatinine, uric acid • Neurologic – Regression of HA – Reflexes return to normal
Postpartum • Renal – Improvement in urine output – Large diuresis sign of recovery – Improvement in BUN, creatinine, uric acid • Neurologic – Regression of HA – Reflexes return to normal
 Postpartum • Subjective improvement – Treat until signs of improvement – If mom isn’t feeling well, she isn’t well – Keep Mg. SO 4 running until signs the disease is regressing and mom feels better
Postpartum • Subjective improvement – Treat until signs of improvement – If mom isn’t feeling well, she isn’t well – Keep Mg. SO 4 running until signs the disease is regressing and mom feels better
 A woman in PTL was receiving IV Mg. SO 4. Despite treatment, precipitous labor & birth occurred. Oxytocin was ordered after delivery of placenta. Instead of oxytocin, the Mg. SO 4 was infused at a rapid rate. (The Mg. SO 4 infusion had been DC’d and the IV line removed from the pump, but remained connected to the patient at the Y port. ) Pt. returned to her LDR room and VS assessed. Approximately 30 min. later, pt. found unresponsive and not breathing. Code initiated, resuscitation difficult, defibrillation x 3 and 9 minutes to restore HR. Subsequently learned she had ~ 550 ml of the IV Mg. SO 4 (22 g). Despite aggressive Rx, calcium chloride, and ICU care, she did not regain consciousness and remains in a persistent vegetative state. MCN, May/June 2004
A woman in PTL was receiving IV Mg. SO 4. Despite treatment, precipitous labor & birth occurred. Oxytocin was ordered after delivery of placenta. Instead of oxytocin, the Mg. SO 4 was infused at a rapid rate. (The Mg. SO 4 infusion had been DC’d and the IV line removed from the pump, but remained connected to the patient at the Y port. ) Pt. returned to her LDR room and VS assessed. Approximately 30 min. later, pt. found unresponsive and not breathing. Code initiated, resuscitation difficult, defibrillation x 3 and 9 minutes to restore HR. Subsequently learned she had ~ 550 ml of the IV Mg. SO 4 (22 g). Despite aggressive Rx, calcium chloride, and ICU care, she did not regain consciousness and remains in a persistent vegetative state. MCN, May/June 2004
 A woman with preeclampsia being transferred to a tertiary care center was receiving IV Mg. SO 4 at 2 g/hr. Because the maternal transport team was not available, a critical care nurse was selected to accompany the patient. Illegibly written orders to continue the mag sulfate at 2 g/hr were interpreted by the nurse to be 7 g/hr, and the dosage was adjusted accordingly. The patient appeared stable , was noted to be sleeping during the last portion of the trip, and found to have respirations of 10/min. on arrival. The error in order interpretation and dosage was discovered by nurses at the accepting institution. Calcium gluconate was administered and respiratory status improved quickly.
A woman with preeclampsia being transferred to a tertiary care center was receiving IV Mg. SO 4 at 2 g/hr. Because the maternal transport team was not available, a critical care nurse was selected to accompany the patient. Illegibly written orders to continue the mag sulfate at 2 g/hr were interpreted by the nurse to be 7 g/hr, and the dosage was adjusted accordingly. The patient appeared stable , was noted to be sleeping during the last portion of the trip, and found to have respirations of 10/min. on arrival. The error in order interpretation and dosage was discovered by nurses at the accepting institution. Calcium gluconate was administered and respiratory status improved quickly.
 A woman w/PTL had orders for 6 g load of Mg. SO 4 to be followed by 3 g/hr. Mainline IV fluids of LR were TRA 300 ml/ hr. RN mixed 40 gm of Mg. SO 4 in 1 L LR and labeled the bag. The RN gave the 6 g loading dose without an infusion device and then used a pump to give the Mg. SO 4 and mainline fluids. Over next 3 hrs, woman reported feeling flushed/nauseated. DTRs not assessed. RR < to 10. RN assured woman/family these symptoms were expected. Woman eventually appeared to be sleeping deeply, RN assumed she needed rest after the stress of being admitted w/PTL. Pt’s family left for dinner, upon return found the woman not breathing. RN called to room and could not palpate a pulse. Code initiated but was unsuccessful. Mg toxicity suspected, IV fluids sent for analysis. Discovered the bags had been mislabeled, received 12 g/hr x 3 hours.
A woman w/PTL had orders for 6 g load of Mg. SO 4 to be followed by 3 g/hr. Mainline IV fluids of LR were TRA 300 ml/ hr. RN mixed 40 gm of Mg. SO 4 in 1 L LR and labeled the bag. The RN gave the 6 g loading dose without an infusion device and then used a pump to give the Mg. SO 4 and mainline fluids. Over next 3 hrs, woman reported feeling flushed/nauseated. DTRs not assessed. RR < to 10. RN assured woman/family these symptoms were expected. Woman eventually appeared to be sleeping deeply, RN assumed she needed rest after the stress of being admitted w/PTL. Pt’s family left for dinner, upon return found the woman not breathing. RN called to room and could not palpate a pulse. Code initiated but was unsuccessful. Mg toxicity suspected, IV fluids sent for analysis. Discovered the bags had been mislabeled, received 12 g/hr x 3 hours.
 Woman 4 days PP presented to ED in small rural hospital with c/o severe HA, blurred vision, epigastric pain. BP 168/110 and 4+ pitting edema in legs. ER MD ordered Mg. SO 4 to be given (2 g load followed with 1 g/hr). A premixed bag of 40 g/1000 ml fluid sent to ED. Together, the ED MD and RN calculated the infusion rate for the pump to deliver 1 g/hr. Jointly decided that 250 ml was the correct infusion rate. Two hrs after the infusion started, woman transferred to PP unit. Report abbreviated because ED was busy. The admitting nurse noted the 250 ml rate and assumed the Mg. SO 4 must have been discontinued and that this rate was the mainline bag, because she knew 250 ml/hr was too high for Mg. SO 4. Did not confirm rate and contents of each line. Approx. 30 min. later, pt’s husband called to say his wife was feeling weak & unable to move. Error noted when pt. reassessed. Pt. had received 25 g Mg. SO 4 over 2. 5 hrs. Calcium gluconate given, pt. rapidly improved.
Woman 4 days PP presented to ED in small rural hospital with c/o severe HA, blurred vision, epigastric pain. BP 168/110 and 4+ pitting edema in legs. ER MD ordered Mg. SO 4 to be given (2 g load followed with 1 g/hr). A premixed bag of 40 g/1000 ml fluid sent to ED. Together, the ED MD and RN calculated the infusion rate for the pump to deliver 1 g/hr. Jointly decided that 250 ml was the correct infusion rate. Two hrs after the infusion started, woman transferred to PP unit. Report abbreviated because ED was busy. The admitting nurse noted the 250 ml rate and assumed the Mg. SO 4 must have been discontinued and that this rate was the mainline bag, because she knew 250 ml/hr was too high for Mg. SO 4. Did not confirm rate and contents of each line. Approx. 30 min. later, pt’s husband called to say his wife was feeling weak & unable to move. Error noted when pt. reassessed. Pt. had received 25 g Mg. SO 4 over 2. 5 hrs. Calcium gluconate given, pt. rapidly improved.


